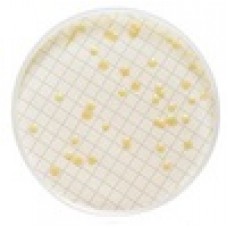
MILLIFLEX MEIO TRYPTIC SOY AGAR CONTAGEM TOTAL HETEROTROFICOS CONF. USP/EP VALIDADE MINIMA: 3 MESES (CX) MILLIPORE
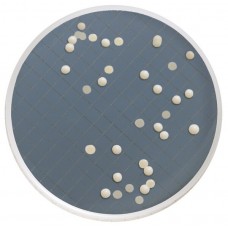
MILLIFLEX CASSETE DE INCUBAÇÃO PRÉ-ENVASADO C/ MEIO SABOURAUD DEXTROSE AGAR MILLIPORE (48 UND)

PEPTONA UNIVERSAL M 66 (NEO PEPTONE) P/ MICROBIOLOGIA MERCK (EMB. 1KG)
Modelo: 1070431000
R$8.948,55
MILLIFLEX MEIO M ENDO LES AGAR COLIFORMES CONF. STD METHODS VALIDADE MINIMA: 3 MESES (CX) MILLIPORE
Modelo: MXSMEND48
R$3.995,71
MILLIFLEX CASSETE DE INCUBAÇÃO PRÉ-ENVASADO C/ MEIO SABOURAUD DEXTROSE AGAR MILLIPORE (48 UND)
Modelo: MXSMCSD48
R$4.082,89
MEMBRANA ULTRACEL PLCC 5KNMWL DIAM 90mm CELULOSE REGENERADA (CX) MILLIPORE
Modelo: PLCC09005
R$2.028,42
MEMBRANA ULTRACEL PLCC 5KNMWL DIAM 76mm CELULOSE REGENERADA (CX) MILLIPORE
Modelo: PLCC07610